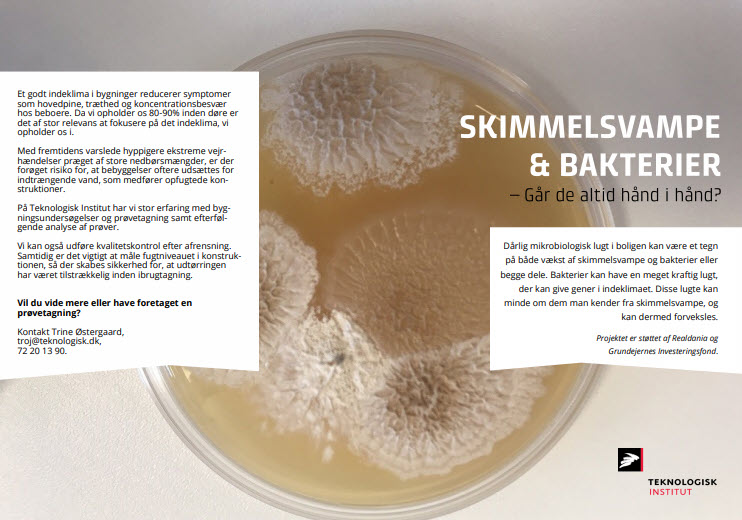
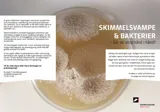

Fugt
Opstigende grundfugt
Tørskæring
Kælderguiden er én samlet indgang til al relevant viden om kælderbrug i beboelsesejendomme. Få gode råd om, hvordan du opbevarer ting bedst samt vedligeholder din kælder. Få enkel og præcis vejledning i håndtering af skader, hvis uheldet er ude.
Kælderguiden.dk
Kælderguiden er én samlet indgang til al relevant viden om kælderbrug i beboelsesejendomme. Få gode råd om, hvordan du opbevarer ting bedst samt vedligeholder din kælder. Få enkel og præcis vejledning i håndtering af skader, hvis uheldet er ude.
4 dampspærresystemer af ny jomfruelig plast og 5 systemer af genbrugsplast er gennemtestet på kryds og tværs i et stort samarbejde med 4 forskningsinstitutioner.
Test af dampspærre af henholdsvis ny- og genbrugsplast
4 dampspærresystemer af ny jomfruelig plast og 5 systemer af genbrugsplast er gennemtestet på kryds og tværs i et stort samarbejde med 4 forskningsinstitutioner.
Opstigende grundfugt
Tørskæring
Kælderguiden er én samlet indgang til al relevant viden om kælderbrug i beboelsesejendomme. Få gode råd om, hvordan du opbevarer ting bedst samt vedligeholder din kælder. Få enkel og præcis vejledning i håndtering af skader, hvis uheldet er ude.
Kælderguiden.dk
Kælderguiden er én samlet indgang til al relevant viden om kælderbrug i beboelsesejendomme. Få gode råd om, hvordan du opbevarer ting bedst samt vedligeholder din kælder. Få enkel og præcis vejledning i håndtering af skader, hvis uheldet er ude.
4 dampspærresystemer af ny jomfruelig plast og 5 systemer af genbrugsplast er gennemtestet på kryds og tværs i et stort samarbejde med 4 forskningsinstitutioner.
Test af dampspærre af henholdsvis ny- og genbrugsplast
4 dampspærresystemer af ny jomfruelig plast og 5 systemer af genbrugsplast er gennemtestet på kryds og tværs i et stort samarbejde med 4 forskningsinstitutioner.

Skybrudssikring af bygninger
Der er mange ting, du selv kan gøre for at mindske risikoen for, at din ejendom tager skade ved skybrud.

MEMBRAN-ERFA
Gennem kortfattede, let forståelige beskrivelser og illustrationer af bygningsdetaljer og udførelsesmetoder, giver denne hjemmeside eksempler på forskellige membranløsninger.

Skybrudssikring af bygninger
Der er mange ting, du selv kan gøre for at mindske risikoen for, at din ejendom tager skade ved skybrud.

MEMBRAN-ERFA
Gennem kortfattede, let forståelige beskrivelser og illustrationer af bygningsdetaljer og udførelsesmetoder, giver denne hjemmeside eksempler på forskellige membranløsninger.